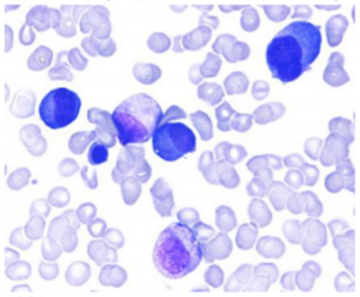

多发性骨髓瘤(MM)是一种克隆性浆细胞异常增殖的血液系统恶性肿瘤,其不可治愈性决定了治疗理念需从追求短期缓解向“深度持久缓解+长期慢病管理”转变。随着蛋白酶体抑制剂(PI)、免疫调节剂及单克隆抗体等新型药物的不断涌现,新诊断MM(NDMM)的治疗已形成“诱导治疗-移植/巩固-持续治疗”的全程管理模式。在这一模式中,诱导/移植后的持续治疗是巩固疗效、延缓进展、改善远期预后的关键环节。基于硼替佐米(V)或达雷妥尤单抗(Dara)的诱导方案,虽能快速降低肿瘤负荷,但其长期应用可能面临毒性累积风险。而伊沙佐米(I)作为新一代口服PI,以其良好的生存获益、可控的安全性及便捷的给药方式,为需要长期治疗的MM患者,尤其是从其他方案转换而来的患者,提供了更具可行性的持续治疗选择。
为进一步验证“达雷妥尤单抗诱导序贯伊沙佐米持续治疗”策略在真实世界中的临床价值,【肿瘤资讯】特邀华中科技大学同济医院学院附属同济医院王迪教授与重庆医科大学附属第一医院王利教授,基于一项回顾性研究数据,并结合其中两例典型病例,对该策略的有效性、安全性及适用性进行系统剖析,以期为MM患者的个体化全程管理提供真实世界证据支持。
转换至以伊沙佐米为基础方案治疗MM的疗效与安全性综合评估
研究设计与基线特征
该研究为单中心回顾性真实世界研究,纳入118例于2023年1月~2025年3月就诊、符合2014 IMWG诊断标准的成人MM患者。研究采用的治疗方案以IRd(伊沙佐米+来那度胺+地塞米松)为主(45.6%),当患者对来那度胺或地塞米松不耐受时,可调整为IR或Id方案,治疗周期为28天,伊沙佐米给药剂量为3~4mg(每个周期的第1、8、15天)。
截止至2025年6月,基线数据分析显示,入组患者中位年龄为61岁(36~83岁),其中≥65岁者占40.0%;男性患者占59.1%;R-ISS分期Ⅲ期患者占33.9%,mSMART4.0高危患者占30.0%;细胞遗传学异常中,1q21扩增阳性率最高(36.5%),其次为t(4;14)(10.4%)、TP53异常(5.2%)等。
根据治疗转换背景,患者分为含V方案转换组(81例,69%)与不含V方案转换组(37例,31%)。其中不含V方案转换组包括,含Dara方案转换亚组10例,其他方案转换亚组27例。
疗效分析:多场景下的深化缓解与持久控制
在含V方案转换亚组中,NDMM患者(67例,83%)转换前ORR为76.3%,其中sCR/CR率28.8%、VGPR率17.0%、PR率30.5%;转换为伊沙佐米方案后,ORR提升至94.9%,sCR/CR率升至39.0%,VGPR率25.4%,≥VGPR率达64.4%,中位治疗周期7个(1~27个),49.3%的患者仍在持续治疗(图1)。

而在含V方案转换的复发/难治MM(RRMM)亚组(14例,17%)中,转换前ORR仅34.6%,且无sCR/CR患者,63.5%的患者处于疾病进展(PD)状态;转换后ORR达100.0%,27.3%的患者实现sCR/CR,63.3%达PR,无PD患者,中位治疗周期5个(1~12个),28.6%的患者仍在接受治疗(图2)。

其次,在含Dara方案转换亚组中,8例可评估患者转换前ORR为75.0%,sCR/CR率37.5%、VGPR率25.0%、PR率12.5%、PD率12.5%;转换为伊沙佐米方案后,ORR升至100.0%,sCR/CR率提升至50.0%,37.5%达PR,无PD患者,中位治疗周期4个(2~12个),60.0%的患者仍在持续治疗,30%的患者缓解深度进一步加深。

最后,在其他方案转换亚组中,27例患者转换前85.0%未评估基线疗效,仅15.0%达PR;转换为伊沙佐米方案后,sCR/CR率达45.0%,VGPR率25.0%,PR率20.0%,≥VGPR率70.0%,中位治疗周期6个(1~16个),40.7%的患者仍在持续治疗,40.0%的患者后续接受了移植治疗。

安全性分析:低毒可控,耐受性良好
全组16.9%(20/118)的患者出现至少1种不良反应,最常见的为胃肠道不适(恶心呕吐、腹泻),其次为骨髓抑制、皮肤瘙痒及周围神经病变(PN)。值得注意的是,含V方案转换组中,17例患者因出现PN转换至伊沙佐米方案,仅1例患者PN未缓解脱落,其余16例患者PN未进一步加重,均未因PN中断治疗,证实伊沙佐米在规避神经毒性累积方面的显著优势。全组无严重感染、严重心血管不良反应等致命性不良事件发生,治疗耐受性良好,患者依从性高。
病例一
患者概况
患者女性,54岁,2021年9月无明显诱因出现反复肋骨自发性骨折,外院检查提示免疫固定电泳IgG-κ型,2021年11月至华中科技大学同济医学院附属同济医院血液科就诊。既往无特殊病史,体格检查未见明显异常。
检查结果
血常规:血红蛋白 94g/L。
生化:白蛋白 39.2g/L,乳酸脱氢酶 120U/L,钙 2.35mmol/L,肌酐 65umol/L,β2微球蛋白 1.85mg/L。
单克隆丙种球蛋白:血中有IgG-κ型蛋白,M蛋白绝对值29.5g/L,血清游离轻链κ 31.7mg/ml。
MR:腰椎退行性病变,右侧髂骨局灶性骨质水肿。
CT:左肺上叶及双肺下叶散在微结节。
心电图:窦性心动过缓
骨髓细胞涂片:原始浆/幼稚浆细胞占9%。
骨髓组织活检:单克隆浆细胞明显增生,约占30%,限制性表达κ。

流式细胞术:可见异常浆细胞群;
FISH:1q21扩增(3个拷贝数)、RB1基因缺失、IGH基因不典型重排或5’伴缺失、MAF基因缺失、FGFR3基因扩增。
诊断
1. 多发性骨髓瘤(IgG-κ型,DS Ⅲ期A,R-ISS Ⅰ期);2. 骨质破坏。
治疗经过
2021年11月~2022年1月:予VRd方案(硼替佐米+来那度胺+地塞米松)治疗2个疗程,期间患者出现手指尖麻木,考虑硼替佐米相关PN。
2022年1月~2022年4月:调整为DRd方案(达雷妥尤单抗+来那度胺+地塞米松)治疗4个疗程,2022年3月疗效评估达PR。
2022年5月:行自体造血干细胞移植(ASCT),2022年9月疗效评估达CR。
2022年9月~2023年1月:予DRd方案巩固治疗3个疗程,2023年1月疗效评估达sCR。
2023年1月至今:予IRd(伊沙佐米+来那度胺+地塞米松)方案全口服持续治疗,持续保持sCR状态。
疗效与转归
患者接受IRd方案持续治疗期间,定期复查骨髓形态学、流式细胞术、血/尿免疫固定电泳等指标,均提示未见异常浆细胞,微小残留病(MRD)持续阴性,血清M蛋白持续转阴,未再出现PN加重或其他不良反应。治疗期间患者仅需定期门诊随访,居家口服给药,生活质量良好,治疗依从性高。
病例小结
该例患者为高危遗传学异常合并骨质破坏的NDMM患者,初始VRd方案治疗后出现PN,转换为达雷妥尤单抗为基础的诱导治疗后获得PR,ASCT后达CR,后续采用IRd全口服方案持续治疗,实现了长达36个月的sCR。病例证实,存在高危遗传学异常患者,采用“Dara诱导序贯I持续治疗”的策略,不仅能深化缓解深度,使患者持续保持sCR状态,还能规避神经毒性风险,口服给药模式显著提升了长期治疗的可行性。
病例二
患者概况
患者男性,68岁,2021年3月因尿蛋白、血尿就诊,无尿急尿痛、腰痛等不适,肾功能正常。既往有高血压、前列腺癌术后病史,体格检查示腹软,可见腹腔镜手术疤痕,左下腹小片色素沉着性皮疹,其余未见明显异常。
检查结果
血常规:血红蛋白 77g/L。
生化:白蛋白 36g/L,乳酸脱氢酶 108U/L,钙 2.28mmol/L,肌酐 76umol/L。
血清免疫固定电泳:IgA-λ型M蛋白,β球蛋白+M蛋白绝对值20.1g/L,血清游离轻链λ 421.3mg/ml。
MR:早期心肌淀粉样变性不排除。
PET-CT:骨髓代谢轻度增高,左侧锁骨上、纵隔等部位小淋巴结增多。
心电图:窦性心动过缓。
骨髓细胞涂片:原始浆/幼稚浆细胞占57%。

骨髓组织活检:幼稚浆细胞弥漫性增生,约占80%,免疫组化CD38+、CD138+、λ+。

流式细胞术:约12.5%的细胞为单克隆性异常浆细胞。
FISH:1q21扩增(3个拷贝数)、RB1基因缺失、IGH基因断裂重排伴缺失、MAF基因缺失。
诊断
1.多发性骨髓瘤(IgA-λ型,DS Ⅲ期A,高危);2. 心脏淀粉样变性(早期可能);3. 中度贫血;4. 高血压性心脏病;5. 脑缺血灶/腔梗灶;6. 外周动脉粥样硬化;7. 慢性胃炎;8. 前列腺癌根治术后;9. 双侧腹股沟疝;10. 焦虑症。
治疗经过
2021年3月~2021年6月:予VRd方案治疗4个疗程,同时予以保护骨质、护肝护胃、营养神经、护心等对症支持治疗。
2021年8月:采集干细胞,并行Dd方案(达雷妥尤单抗+地塞米松)治疗3个疗程,2021年10月疗效评估达CR。
2021年12月:行ASCT,2022年3月疗效评估达sCR。
2022年3月~2022年8月:予DRd方案巩固治疗6个疗程。
2022年9月至今:予IRd方案(伊沙佐米+来那度胺+地塞米松)全口服持续治疗,持续保持sCR状态。
疗效与转归
患者接受IRd方案持续治疗期间,疗效持续稳定,血/尿免疫固定电泳持续阴性,骨髓形态学及MRD检测未见异常浆细胞,心脏淀粉样变性相关指标无进展,高血压等基础疾病控制良好,未出现感染、腹泻、神经毒性等不良反应。患者治疗期间仅需半年一次回院复查,居家口服给药即可,经济负担轻,生活质量较高,整体治疗满意度良好。
病例小结
该例患者为高龄、高危MM合并多系统基础疾病,治疗耐受性差,初始经VRd方案诱导及达雷妥尤单抗巩固后获得CR,ASCT后达sCR,后续采用IRd全口服方案持续治疗,实现了持续稳定的sCR。病例充分证实,对于高龄、合并症多、体能状态差的MM患者,“Dara诱导序贯I持续治疗”策略能在保证疗效的同时,最大限度降低治疗相关风险,口服给药模式契合老年患者的长期治疗需求。


特邀专家
重庆医科大学附属第一医院血液科主任
中华医学会血液学分会第十二届全国委员
中国医师协会血液科医师分会全国委员
中华医学会血液学分会白血病-淋巴瘤学组委员
中国抗癌协会血液肿瘤专委会髓系肿瘤学组委员
中国抗癌协会血液肿瘤专委会MDS与MPN学组委员
中国抗癌协会肿瘤多学科诊疗专委会委员
中国抗癌协会肿瘤临床研究管理学专委会委员
重庆市医学会血液学分会副主任委员
重庆市医师协会血液学分会副主任委员
重庆抗癌协会血液肿瘤专委会副主任委员
重庆抗癌协会淋巴瘤专委会副主任委员
重庆市中西医结合协会精准医学专委会副主任委员
重庆市医药生物技术协会生免治疗专委会副主任委员
重庆市医院管理协会血液科分会委员
先后在英国牛津大学攻读博士后、巴黎圣路易医院研学。主持国自然、教育部等多项科研课题,发表论文50余篇,其中SCI论文30多篇
华中科技大学同济医学院附属同济医院血液内科
中国老年学和老年医学学会老年病学分会血液(湖北)专委会秘书长
湖北省医学生物免疫学会血液免疫专委会细胞因子调控分会常委
湖北省医学生物免疫学会细胞治疗专委会委员
主持和参与多项国家自然科学基金
多次在ASH、EHA等会议作Oral Presentation
以第一作者和通讯作者在Blood、Blood Cancer Journal等杂志发表多篇论文
[1]Rifkin RM, Girnius SK, Noga SJ, et al. In-class transition (iCT) of proteasome inhibitor-based therapy: a community approach to multiple myeloma management. Blood Cancer J. 2023 Sep 19;13 (1):147.
[2]Moreau P, Masszi T, Grzasko N, et al. Oral Ixazomib, Lenalidomide, and Dexamethasone for Multiple Myeloma. N Engl J Med. 2016 Apr 28;374 (17):1621-34.
[3]Leleu X, Lee HC, Zonder JA, et al. INSURE: a pooled analysis of ixazomib-lenalidomide-dexamethasone for relapsed/refractory myeloma in routine practice. Future Oncol. 2024 May;20 (14):935-950.
[4]Richardson PG, Hofmeister CC, Rosenbaum CA, et al. Twice-weekly ixazomib in combination with lenalidomide-dexamethasone in patients with newly diagnosed multiple myeloma. Br J Haematol. 2018;182 (4):578-587.
[5]Vassilopoulos S, Vassilopoulos A, Kalligeros M, et al. Cumulative Incidence and Relative Risk of Infection in Patients With Multiple Myeloma Treated With Anti-CD38 Monoclonal Antibody-Based Regimens: A Systematic Review and Meta-analysis. Open Forum Infect Dis. 2022 Oct 31;9 (11):ofac574.
[6] 伊沙佐米药品说明书.
排版编辑:肿瘤资讯-Alex






苏公网安备32059002004080号